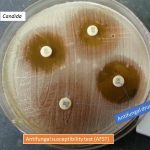
Antifungal drugs and its susceptibility test

Collection Group: Mycology
Fungal Infection Site: Introduction, Importance of Fungal Infection and Its Lab Diagnosis
 Fungal Infection Site The fungal infection site is due to...
Fungal Infection Site The fungal infection site is due to...
Fungal Hyphae in KOH Preparation of Pus Discharge in Details
 Fungal hyphae in KOH Preparation of Pus Discharge Fungal hyphae...
Fungal hyphae in KOH Preparation of Pus Discharge Fungal hyphae...
Antifungal Drugs Susceptibility Testing: Introduction, Mode of Action, Test Procedure, Result Interpretation and Keynotes
Introduction of Antifungal Drugs Susceptibility Testing Antifungal drugs and their...
Introduction of Antifungal Drugs Susceptibility Testing Antifungal drugs and their...
